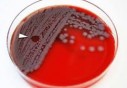

Traversée sur le Tariq Ibn Ziyad : L’ENTMV à la rescousse de la SNCM
Traversée sur le Tariq Ibn Ziyad : L’ENTMV à la rescousse de la SNCM
-
 Santé
31-07-2015 | 16:46
Santé
31-07-2015 | 16:46Le pr Smail Mesbah est formel : «Le décès signalé récemment à l’hôpital de Djelfa n’a pas été causé par le botulisme»
-
 Santé
31-07-2015 | 16:42
Santé
31-07-2015 | 16:42Le fait de se tenir plus souvent debout pourrait contribuer à nous maintenir en bonne santé
-
 Santé
31-07-2015 | 16:41
Santé
31-07-2015 | 16:41Ebola : Nouveaux cas au plus bas depuis un an, mais inquiétude pour la Sierra Leone (OMS)
-
 Santé
31-07-2015 | 16:38
Santé
31-07-2015 | 16:38L'OMS demande plus d'efforts pour lutter contre les hépatites virales
-
Santé
28-07-2015 | 19:07Réalisation de plusieurs maternités à Alger en 2016
-
Santé
28-07-2015 | 19:06L'ONU suspend des programmes de santé en Irak par manque de fonds
-
Santé
28-07-2015 | 19:04Saïda : Le premier service ORL à la polyclinique Chahid Abdelli Mohamed
-
 Santé
24-07-2015 | 18:21
Santé
24-07-2015 | 18:21La chimiothérapie en phase terminale préjudiciable à la qualité de vie
-
Santé
24-07-2015 | 18:19
Santé
24-07-2015 | 18:19Envoi de bacilles mortels : Le Pentagone n'a constaté aucune erreur majeure
Flux RSS DKNEWS-DZ.COM

LES FLASH ACTU
TOUTES LES NEWS
-
Jumelage entre le CHU d’Hussein Dey et l’hôpital de Djelfa: Réalisation de plus de 400 examens médicaux et 75 interventions
Plus de 400 examens médicaux et 75 interventions chirurgicales ont été réalisées par une équipe médicale du CHU Nafissa Hamoud (Ex- Parney) d’Hussein Dey(Alger), au niveau de l’hôpital de Djelfa, dans le cadre d’une opération de jumelage,....
-
Naama: Une caravane de prestations sanitaires sillonne 6 zones éloignées
Une caravane médicale a été lancée dimanche pour prodiguer des services sanitaires aux habitants de six zones et villages éloignés où sont concentrés les nomades au sud de la wilaya de Naama, a-t-on appris des organisateurs.
-
Cliniques privées: Entre impératifs réglementaires et logique commerciale
Les établissements hospitaliers privés (EHP), dont le nombre ne cesse d'augmenter ces dernières années, obéissent plus à une logique commerciale qui assure leur pérennité, au prix d’énormes sacrifices financiers pour les malades, et parfois .....
-
Plaidoyers pour la contractualisation avec la Sécurité sociale
«Tant que la question de la contractualisation avec la Sécurité sociale n'est pas réglée, les tarifs pratiqués par les privés demeureront libres. Il faut un système de santé unique pour le public et le privé, une réglementation qui fasse le pont ....
-
Pharmacie: Le SNAPO appelle à accélérer la publication de la liste des psychotropes
Le Syndicat national algérien des pharmaciens d'officine (SNAPO) a appelé, samedi à Alger, à l'accélération de la publication de la liste des psychotropes destinés à des fins sanitaires dans le but de protéger le pharmacien et le malade.
-
Maladies rares: Nécessité d’un plan national pour une bonne prise en charge
La prise en charge des maladies rares passe par la mise en place d’un plan national assurant notamment le recensement et le diagnostic des cas, a indiqué, jeudi à Alger, le président de l’Association Shifa des maladies neuromusculaires, ....
-
Ghardaïa: Recrudescence de la leishmaniose cutanée et résistance de la brucellose en 2018
Une recrudescence des cas de leishmaniose cutanée et une résistance de la brucellose ont été observées en 2018 dans la wilaya de Ghardaïa, par rapport aux années l'ayant précédées, révèle un bilan de la direction locale de la Santé et de ....
-
Selon l'Agence nationale de sang (ANS):Plus de 290.000 poches de sang collectées durant le premier semestre de 2018
Plus de 290.000 poches de sang ont été collectés à travers les centres de transfusion durant les six (06) premiers mois de 2018, a fait savoir, jeudi à Alger, un responsable à l'Agence nationale de sang (ANS).
L'EDITO
Le Président de la République, Abdelaziz Bouteflika, a reçu hier le Premier ministre français, Jean-Marc Ayrault, en visite officielle en Algérie. L'audience s'est déroulée en présence du Premier ministre, Abdelmalek Sellal. Lors de cette audience...
LIRE LA SUITEPHOTOS & VIDEOS
-
LE FORUM 14-04-2014 | 15:41Mr Abdelaziz Belkhadem au Forum de DK News 14/04/2014
CHRONIQUES
-
 Walid B
Walid B
Grâce à des efforts inlassablement consentis et à une efficacité fièrement retrouvée, la diplomatie algérienne, sous l’impulsion de celui qui fut son artisan principal, en l’occurrence le président de la République Abdelaziz Bouteflika, occupe aujour
-
 Boualem Branki
Boualem Branki
La loi de finances 2016 n’est pas austère. Contrairement à ce qui a été pronostiqué par ‘’les experts’’, le dernier Conseil des ministres, présidé par le Président Bouteflika, a adopté en réalité une loi de finances qui prend en compte autant le ress
-
 Walid B
Walid B
C'est dans le contexte d'un large mouvement de réformes sécuritaires et politiques, lancé en 2011, avec la levée de l'état d'urgence et la mise en chantier de plusieurs lois à portée politique, que ce processus sera couronné prochainement par le proj
-
 Boualem Branki
Boualem Branki
La solidité des institutions algériennes, la valorisation des acquis sociaux et leur développement, tels ont été les grands messages livrés hier lundi à Bechar par le ministre de l'Intérieur et des Collectivités locales Nouredine Bédoui.
-
 DK NEWS
DK NEWS
Le gouvernement ne semble pas connaître de répit en cette période estivale. Les ministres sont tous sur le terrain pour préparer la rentrée sociale qui interviendra début septembre prochain.
-
 Walid B
Walid B
Dans un contexte géopolitique régional et international marqué par des bouleversements de toutes sortes et des défis multiples, la consolidation du front interne s'impose comme unique voie pour faire face à toutes les menaces internes..
-
 Walid B
Walid B
Après le Sud, le premier ministre Abdelmalek Sellal met le cap sur l'Ouest du pays où il est attendu aujourd'hui dans les wilayas d'Oran et de Mascara pour une visite de travail et d'inspection.









 MAMI : Au cœur d’une usine algérienne de production de boissons gazeuses et de jus algériens
MAMI : Au cœur d’une usine algérienne de production de boissons gazeuses et de jus algériens  Laiterie Soumam : Les secrets d’une réussite
Laiterie Soumam : Les secrets d’une réussite  Lutte contre la drogue : Signature d’un accord entre le ministère des Affaires religieuses et l’ONLDT
Lutte contre la drogue : Signature d’un accord entre le ministère des Affaires religieuses et l’ONLDT 

